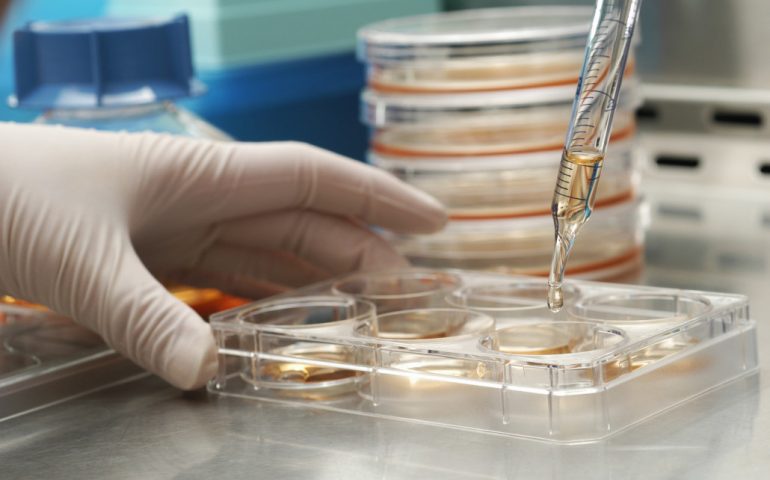

Staminali superstar: sesto appuntamento al Caffè Sette Vizi con la rassegna Dialoghi di Scienza
Tra i rettili più affascinanti e poco conosciuti della Sardegna spicca un serpente raro e spettacolare: il Colubro sardo, comunemente chiamato “colubro a ferro di cavallo”, per via delle particolari barre scure presenti sul capo, disposte in modo da ricordare proprio la forma di un ferro di cavallo.
Per molto tempo, la sua presenza nell’isola è stata avvolta nel mistero, tanto che si pensava fosse una creatura leggendaria. Eppure, questo serpente esiste eccome! È stato avvistato con certezza in alcune zone dell’Oristanese e del Cagliaritano, inclusi ambienti naturali urbani come le aree centrali del Parco di Molentargius, nel territorio di Cagliari e Quartu Sant’Elena.
Il suo aspetto è imponente, come spiegano bene gli amici di Sardegna Foreste: può raggiungere facilmente un metro e mezzo di lunghezza, con esemplari eccezionali che superano i 170 cm. La livrea è davvero notevole: fondo scuro, quasi nero, attraversato da una complessa rete di motivi gialli e un ventre acceso, di colore arancione. I giovani, invece, sono più chiari, con tonalità che vanno dal bianco sporco al grigio, decorati da macchie romboidali marroni e zone color crema.
Il colubro è un predatore versatile. Si nutre di piccoli rettili, uccelli e micromammiferi, che può cacciare sia durante il giorno che nelle ore notturne. La stagione degli amori cade in primavera, tra aprile e maggio, con la deposizione delle uova (da 5 a 10 per covata) in zone protette come buche nella sabbia o anfratti tra le pietre. I piccoli nascono a fine estate, fra agosto e settembre.
In caso di pericolo, questo serpente può diventare aggressivo e mordere, ma lo fa solo se non ha possibilità di fuga. Nonostante l’aspetto minaccioso, è una specie non velenosa, e come molte altre, preferisce evitare il contatto con l’uomo.
Oltre alla Sardegna, il colubro a ferro di cavallo è presente anche nella regione maghrebina del Nord Africa e nella penisola iberica.